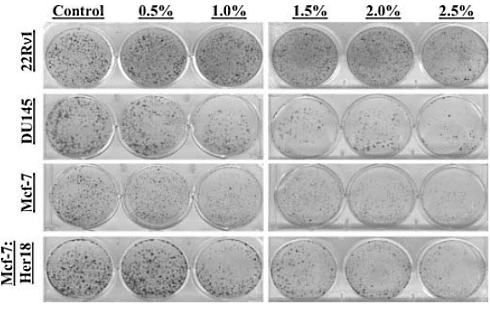

|
An anti-cancer factor in the skin of apples
We recently wrote about an in vitro study in which Pink Lady apple peel extracts inhibited the growth of cancer cells. Probably the skin of all types of ruddy apples has this effect. Today we stumbled upon a similar study from more than a decade ago, in which the skin of Gala apples [see a few below] also inhibited cancer cells.

Study
In 2010, in a paper in Nutrition and Cancer, researchers from the University of Wisconsin told that they had made a water-based extract from organically cultivated Gala apples. They then exposed two types of prostate cancer cells [CWR22Rv1 and DU145] and two types of breast cancer cells [Mcf-7 and Mcf-7:Her18] to different concentrations of that extract.
Results
When the researchers exposed the cells to the extract for 48 hours, they counted the number of cells. The higher the concentration of extract, the lower the number of cancer cells.


The extracts forced the cancer cells to produce more of the enzyme mammary serine protease inhibitor or maspine. This enzyme inhibits the growth, development and metastasis of at least a number of breast cancer cell types.
The effect was most prominent in the MCF7:Her18 cell line. This is an estradiol-sensitive breast cancer cell that no longer responds to tamoxifen.
Conclusion
"We suggest that apple peel extract possesses strong antiproliferative effects against cancer cells, and apple peels should not be discarded from the diet", write the Americans.
"Waste apple peels from applesauce and canned apple manufacture could serve as valuable ingredients that may help in prevention of chronic diseases including cancer."
Source:
Nutr Cancer. 2010;62(4):517-24.
More:
More apples, less lung cancer 22.01.2021
Apples protect better against cancer if you don't peel them 13.05.2020
Archives:
Cancer Prevention & Survival
Prostate Cancer
Breast Cancer
Apples
|